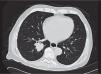

El cáncer renal es una de las 10 primeras entidades malignas en el adulto, globalmente se diagnosticará un estimado de 270,000 nuevos casos y morirán 116,000 anualmente. La variedad sarcomatoidea puede ser encontrada de un 1% a 8% de los pacientes con tumor renal, afectando típicamente a los pacientes entre 56 a 61 años mayormente hablando. Presenta síntomas al momento de su diagnóstico hasta en un 90% de los casos debido a la metástasis, siendo el dolor y la hematuria los principales; con metástasis múltiples hasta en un 47% desde el inicio del estudio, con una mediana de 13 meses de sobrevida desde el diagnóstico, y de 6 a 9 meses cuando se acompaña de metástasis.
El propósito del presente trabajo es presentar un artículo de revisión multicéntrica utilizando la base informática Medline para identificar la epidemiologia, incidencia, potencial metastásico y mortalidad de la variante sarcomatoide de los tumores renales, así como hacer el reporte de un caso en nuestra unidad hospitalaria.
Se presenta paciente masculino 65 años de edad, con antecedentes de tabaquismo intenso por 10 años, además de ser hipertenso de reciente diagnóstico, inicia su padecimiento con hematuria macroscópica indolora formadora de coágulos, se realiza tomografía (TC) de abdomen donde se evidencia tumor renal polo inferior sin evidencia de actividad metastásica en ese momento; es llevado a nefrectomía radical en agosto de 2012, reportando tumor 12x10cm, T4N0M0 variante sarcomatoide, se cita para seguimiento pero llega 2 meses después de la cirugía al Servicio de Urgencias por presentar aumento de volumen testicular izquierdo, astenia, adinamia, disnea de medianos esfuerzos, adenopatía submentoniana y mal estado general; se realiza TC torácica la cual demuestra intensa actividad metastásica además de ultrasonograma testicular donde destaca imagen heterogénea con áreas hipoecoicas, es llevado a orquiectomía radical reportando tumor de células renales sarcomatoide metastásico, es enviado a quimioterapia adyuvante pero reingresa mes y medio después de su última cirugía con franco deterioro, disnea a leves esfuerzos, por lo que se envía a cuidados domiciliarios por máximo beneficio.
Kidney cancer is one of the first 10 malignant entities in the adult. Its overall diagnosis is estimated at 270,000 new cases per year with 116,000 deaths. The sarcomatoid variant can be found in 1% to 8% of the patients with renal tumor, typically affecting patients between the ages of 56 and 61 years. There are symptoms at the time of diagnosis in up to 90% of patients due to metastasis, and the most common are pain and hematuria; multiple metastases are present in 47% of patients from the beginning of evaluation. Median survival is 13 months from the time of diagnosis, and 6 to 9 months when there is metastasis.
The aim of this work was to present a multicenter review article using the MEDLINE® database to identify epidemiology, incidence, metastatic potential, and mortality rate of the sarcomatoid variant of renal tumors, as well as to describe a case report from our hospital unit.
A 65-year-old man had a 10-year history of intense smoking and was recently diagnosed with high blood pressure. His illness began with painless, clotforming gross hematuria. An abdominal computed tomography (CT) scan showed a tumor on the lower pole of the left kidney with no apparent evidence of metastasis. He underwent radical nephrectomy in August 2012 that reported a T4 N0 M0 12 x 10cm sarcomatoid tumor. He was scheduled for followup but appeared at the emergency department 2 months after surgery with an increase in volume of the left testis, asthenia, adynamia, mediumeffort dyspnea, submentonian adenopathy, and general malaise. A chest CT revealed intense metastatic activity and a testicular ultrasound showed a heterogeneous image with hypoechoic areas. The patient underwent radical orchiectomy that reported a metastatic sarcomatoid renal cell tumor and he was referred for adjuvant chemotherapy. One month and a half after his latest surgery, the patient was readmitted with a frankly deteriorated status and mildeffort dyspnea. He was referred to home care for maximum benefit.
El cáncer renal fue responsable de la muerte de 12,840 personas sólo en Estados Unidos en el año 2006, el subtipo histológico más común es el carcinoma de células claras (90%), siendo el pico de mayor incidencia en la séptima década de la vida y afectando levemente más a hombre de raza negra1, además de ser una de las primeras 10 causas de cáncer en todas sus presentaciones, aproximadamente cuenta con el 3% de todas las neoplasias del adulto2; globalmente se diagnosticará un estimado de 270,000 nuevos casos y morirán 116,000 anualmente3.
En 1997 se describe la clasificación de Heidelberg en la cual se realiza 4 tipos subclasificatorios de cáncer renal, ya que se observaron diferencias en su histología, citogenética, agresividad y pronóstico entre cada una de ellas, por lo que se dividieron en: convencional (células claras), que es el más común, papilar, cromófobo, ductos colectores y variedad sarcomatoide. Este último se pensaba que era un estado de progresión de un tumor de alto grado, aunque ya se reconoce como una entidad patológica diferente con su propia actividad biológica claramente reconocida; encontrando un grado de diferenciación nuclear de Fuhrman 4 hasta en el 94.7%, y con metástasis clara en el momento del diagnóstico de hasta 55.3% vs. 10%–30%con cáncer renal de células claras4.
La variedad sarcomatoidea puede ser encontrada de un 1% a 8% de los pacientes con tumor renal, afectando típicamente a los pacientes entre 56 a 61 años mayormente hablando, con tumores entre 9–11cm de diámetro al diagnóstico5, y teniendo síntomas al momento de su determinación hasta en un 90% de los casos debido a la metástasis, siendo el dolor y la hematuria los principales; con metástasis múltiples hasta en un 47% desde el inicio del estudio6. La habilidad para diagnosticar esta variante es pobre, al igual que difícil hacerlo por biopsia con aguja fina7.
Presentación del casoPaciente masculino de 65 años de edad, originario de Zúrich, Suiza y residente de México D.F., jubilado exsupervisor de obras públicas, sin antecedentes heredofamiliares de importancia para el caso, es hipertenso de reciente diagnóstico en tratamiento con IECAS, además de haber sido fumador intenso por 10 años suspendiéndolo hacia 20 años, resto interrogados y negados, el cual inicia su padecimiento desde mayo de 2012 cuando acude con médico general por presentar malestar general, así como hematuria macroscópica en una ocasión, la cual se autolimitó, negando dolor abdominal o pérdida de peso en esa ocasión, con ECOG 0, por lo cual al acudir a nuestro Servicio se realiza tomografía (TC) de abdomen, donde se observa tumor renal izquierdo dependiente del riñón izquierdo de 12x17x14cm en porción media y polo inferior, refuerza con el medio de contraste > 20 UH, se estadifica Tc2b (por tamaño), sin involucro vascular. Por esto, se realizan laboratorios prequirúrgicos, los cuales mostraban anemia (Hb 9.7g) normocrómica normocítica, con placa de tórax sin evidencia de actividad metastásica. Se somete a nefrectomía radical el 14 de agosto de 2012, sin problemas durante la cirugía; después de una corta estancia hospitalaria es egresado a domicilio; durante sus citas de control se obtiene reporte histopatológico: carcinoma renal de células claras con patrón sarcomatoide casi en el total del volumen del tumor, con área de necrosis central al tumor de aproximadamente 20%, Fuhrman 4, tamaño del tumor 12x10cm, localizado en el polo inferior, infiltra el seno renal, cápsula, tejido fibroconectivo perirrenal y facia de Gerota; estructuras vasculares del hilio renal, así como glándula suprarrenal sin evidencia de infiltración por la neoplasia, borde quirúrgico de resección libre de neoplasia. En conclusión, T4pN0M0; se inicia seguimiento citando de nuevo con TC toracoabdominal y laboratorios generales, aunque reingresa al Servicio de Urgencias 2 meses después por presentar astenia, adinamia, disnea de medianos esfuerzos, aparición de nódulo submentoniano y aumento de volumen en testículo izquierdo. Se realiza placa de tórax en 2 proyecciones, donde es evidente la aparición imágenes radiopacas múltiples (fig. 1).
Se realiza además ultrasonido gonadal, donde se evidencia imagen heterogénea de toda la pieza francamente con sospecha de neoplasia, con aumento en su vasculatura del teste izquierdo, además de importante tortuosidad de plexo pampiniforme (figs. 2, 3y 4), teste contralateral normal, además TC toracoabdominal con evidencia de múltiples lesiones parenquimatosas hiperdensas mayores de 3cm en parénquima pulmonar, sin evidencia de derrame en espacio pleural (figs. 5y 6).
Después de valoración prequirurgica con reporte ASA II, Goldman II, Kanofsky 80% y laboratorios prequirúrgicos en los cuales destaca de nuevo anemia (Hb 9.1g, Hto 28.8%), con creatinina en 1.5mg, electrolitos, tiempos de coagulación, prueba funcional hepática y deshidrogenasa láctica dentro de parámetros normales, ECOG 2. Se trasfunde de forma prequirúrgica un paquete globular y se realiza orquiectomía radical obteniendo pieza firme no adherida al escroto con cordón libre, es egresado, visto en la consulta externa con reporte de patología: testículo con carcinoma renal de tipo sarcomatoide metastásico, tamaño del tumor de 4.8x3.4cm, cordón espermático libre de células neoplásicas. Es enviado a valoración y tratamiento por parte de Oncología Médica para iniciar quimioterapia, y al Servicio de Cabeza y Cuello para biopsia de adenopatía sospechosa de enfermedad metastásica submentoniana; pero el paciente regresa en diciembre del mismo año al Servicio de Urgencias con mal estado general, en claro deterioro con pérdida ponderal de más de 20Kg, desde su inicio, astenia, hipodinamia y palidez generalizada, con escala ECOG 3; se decide por parte de los familiares continuar sólo con terapia paliativa en casa por máximo beneficio, falleciendo 20 días después.
DiscusiónEn la primera mitad del siglo pasado se conocía el “sarcoma renal” como aquel tumor mal diferenciado en pacientes con estadios altamente avanzados, aunque en estudios posteriores se observaron misma variante en diferentes clases de tumores, por lo cual fue llamado “el estadio final del cáncer renal”, como última indiferenciación del estado tumoral7,8. En aquellos pacientes con tumores no clasificables, los cuales cuentan del 2%–10% según la serie, es muy común encontrar patrón sarcomatoide puro, además el identificar patrón sarcomatoide a cualquier variante tumoral renal, no ha exhibido ningún cambio en el pronóstico o el tratamiento, ya que se ha abordado con diferentes esquemas teniendo en todos un pobre pronóstico, por lo cual es necesario señalarlo como entidad patológica diferente. Aunque en la mayoría de los casos se acompañan de núcleos celulares peor diferenciados, existen aquellos tumores sarcomatoides con núcleos Fuhrman 1 a 2 hasta en un 30%, por lo que sugiere surgir de una separación celular aparte, en lugar de una indiferenciación9.
Cabe señalar que numerosos estudios indican la prevalencia del sexo masculino en la presentación del patrón sarcomatoide (75% aproximadamente)2,4,5.
HistologíaGeneralmente, los tumores renales sarcomatoides de forma macroscópica se describen como: firmes, voluminosos, al corte color blanco a tonos grisáceos10. Se asocia esta variante mayormente al tumor de células claras hasta en un 8.7%, aunque se pueden observar estos componentes en tumores cromófobos, papilares y de células colectoras; la presencia de necrosis se observa hasta en un 90% de los pacientes11, pero se determina como una variante aparte debido a su actividad metabólica y potencial metastásico ya anteriormente comentado4.
En su acercamiento microscópicos se definen los componentes sarcomatoides como imágenes semejantes a fibrosarcoma con intersecciones de fascículos de células fusiformes malignas, además de la posibilidad de encontrar pleomorfismo indiferenciado parecido al histiocitoma fibroso maligno (fig. 7), generalmente no requiere apoyo con estudios especiales como microscopía electrónica, inmunohistoquímica o genética molecular para su diagnóstico. Genéticamente se puede observar una compleja ganancia y pérdida cromosómica, con la falta en el 13q (75%) y 4q (40%)10.
Patrón metastásicoEn pacientes con enfermedad metastásica lo más común es que se observe puramente patrón sarcomatoide en la muestra, sin importar la diferenciación primaria que tenga en el lugar de inicio hasta en el 97%12, en el caso inverso si primero se realiza la metastasectomía y no se encuentra patrón sarcomatoide, el encontrarlo en el primario sería muy difícil9. Entre los sitios más comunes de metástasis se encuentran: cadena ganglionar regional 60%, pulmón 11%, hígado 7.7%, y hueso 3.8%. El porcentaje de variante sarcomatoide en la pieza, también es importante siendo más común la metástasis y el tiempo de muerte a causa de la enfermedad en aquellos que muestran más del 30%12. Un estudio refiere que se pueden encontrar alteraciones del gen p53 5 veces más, en regiones con diferenciación sarcomatoidea13, además de expresar más marcadores como Ki67, VEGF, vimentina y actina14.
Los tumores renales pueden metastatizar virtualmente a cualquier parte del cuerpo15. Pocos realmente son los estudios que investigan los sitios más comunes según el subtipo histológico de las lesiones; llegando en la mayoría de las ocasiones a la conclusión que: los tumores de células claras son los que mayormente tienen metástasis, igualmente es el que más involucra a los ganglios retroperitoneales regionales, así como a nivel pulmonar; los tumores papilares mayormente dan metástasis a los ganglios no regionales, además a sitios menos comunes; la tendencia de los tumores cromófobos es dar más metástasis a sitios múltiples, además de ser el que tiene mayor afinidad para dar metástasis al hígado ajustando el porcentaje de incidencia (tabla 1)16.
En varios estudios siguientes se llega a la conclusión que es menos favorable cuando el sitio de metástasis es múltiple, comparado cuando sólo es en un sitio, siendo estadísticamente significativo (p<0.001), con una mediana de sobrevida de 13 meses pese a tratamiento con cirugía, seguido de terapia adyuvante vs. sobrevida de hasta 31 meses en aquellos con sólo metástasis pulmonares17. En cuanto a la metástasis a distancia a otros órganos, se han reportado como casos clínicos aislados sitios raros como: estómago18, vesícula biliar19, orofaringe20, ventrículo izquierdo21, piel22, amígdalas23, bazo24, páncreas25, glándula pituitaria26, tiroides27, mama28, músculo gemelo29, duodeno30y testículo31.
La incidencia de metástasis de otros órganos hacia el testículo es de 0.3% a 3.6%, siendo las de la próstata las más comunes32, en los reportes se hace referencia que en la mayoría de los casos son por células claras, aunque también se han comunicado tumores cromófobos31. Generalmente, son ipsilaterales y de predominio izquierdo, postulando como posible causa la infiltración de la vena renal y migración del coágulo tumoral hacia la vena testicular33.
Tratamiento local y sistémicoDebido a la naturaleza biológica de este tumor, la terapia radical es la más aceptada cuando se trata de una enfermedad localizada, el papel que juega la nefrectomía parcial en estos pacientes no ha sido bien estudiada por la falta de estudios prospectivos, además ya que se trata de un tumor altamente infiltrante y agresivo, lo recomendado es resecar la unidad renal por completo9. Debido a la ausencia tangible de beneficios al realizarse linfadenectomía en pacientes sometidos a nefrectomía radical con grado de evidencia 1A, no se realiza normalmente, aunque algunos autores recomiendan realizarla si las adenopatías son evidentes, ya que se han evidenciado positividad de los mismos hasta en un 33%34. Aunque la citorreducción es benéfica hablando del tratamiento sistémico con terapia blanco del carcinoma re-nal metastásico con nivel de evidencia 135.
En cuanto al manejo sistémico varios han sido los esquemas utilizados, con reportes aislados de respuesta ya sea parcial o completa9, en la inmunoterapia se ha utilizado la interleucina 2 demostrando en algunos casos sobrevida media de 10 meses vs. 9 meses en aquellos que no se les trató con nada, además de no existir por el momento reportes a largo plazo de sobrevida36; en aquellos pacientes tratados con quimioterapia se han visto más beneficiados los que utilizaron la combinación doxorrubicina con gemcitabina, reportando un paciente con respuesta completa y sobrevida de más de 8 años, aunque hay que tomar en cuenta que son reportes aislados37. Los pacientes sometidos a terapia antiangiogénica han mostrado con sunitinib un beneficio muy limitado con sobrevida de 4 meses38. En aquellos tratados con inhibidores de la tirosinquinasa se han visto resultados poco alentadores con respuesta parciales del 19%, sobrevida libre de progresión de 5.3 meses y sobrevida global de 11.8 meses, también se observó mejor respuesta en aquellos tratados previamente con quimioterapia, y en los que el porcentaje de tumor sarcomatoide fue menor del 20%39. En cuanto a la terapia con mTor en los estudios realizados no se ha incluido esta variante por separado40. Entre otros medicamentos utilizados de forma experimental, se encuentran cetuximab, geldanamicina, y bortezomib, en espera de resultados finales en reportes de seguimiento41.
ConclusionesEn aquellos pacientes que exhiban cualquier porcentaje de tumor con diferenciación sarcomatoide de inicio tienen mal pronóstico, comparado con aquellos de diferentes variantes, además de la presencia de diferentes características patológicas como lo son invasión a la cápsula renal, porcentaje de necrosis dentro del tumor primario, número de metástasis, grado de diferenciación nuclear, así como la invasión vascular, juegan un patrón primordial en la sobrevida enfermedadespecífica de los pacientes; por lo cual es necesario realizar un estudio minucioso de la pieza quirúrgica para poder determinar con mayor exactitud la severidad del cuadro oncológico. Además, debemos tener en cuenta el estado funcional del paciente, ya que conlleva menor sobrevida cuando se presenta la enfermedad con un paciente previamente comórbido; en cuanto al tratamiento, es necesario señalar la pobre ganancia en sobrevida global en pacientes con estadios avanzados de la citorreducción, por lo cual antes de proponer un tratamiento riesgoso y radical, se debe planificar con anterioridad e informar el estado actual del paciente, al mismo y a sus familiares.
Conflicto de interesesLos autores declaran no tener ningún conflicto de intereses.
FinanciamientoNo se recibió patrocinio para llevar a cabo este artículo.